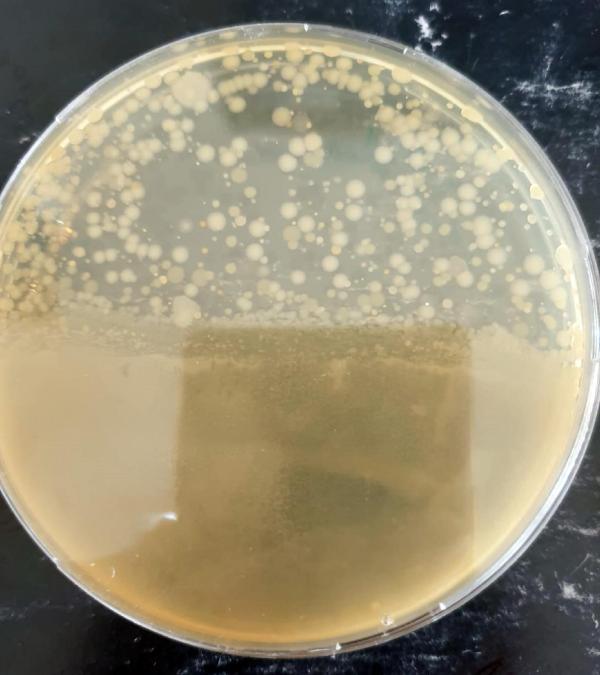
3519d9c8b288a8913b92be90b6467eb3.jpg

Böbrek taşını eritiyor diye içilen suyun mikrop saçtığı ortaya çıktı
Muş’ta böbrek taşını erittiği iddia edilen ve bölge halkının tüm uyarılara rağmen içmeye devam ettiği suyun, mikrop saçtığı belirlendi.

Kent merkezine 40 kilometre uzaklıktaki Gümüşali köyünde çıkan suyun böbrek taşına iyi geldiği iddia edildi. Bunu duyan bölge halkı da köye akın etti. Bidonlara doldurdukları suları alıp, evlerine götürdü.

Muş Alparslan Üniversitesi Afet Yönetim, Uygulama ve Araştırma Merkezi Müdürü Dr. Öğretim Üyesi İskender Dölek de geçen haziran ayında suyla ilgili çalışma başlattı. Dölek, incelenmek üzere sudan numune aldı. Ayrıca bardaklara doldurduğu suya çakıl büyüklüğünde taşlar attı. Bazı taşların 1- 2 dakikada eriyerek yok olduğu gözlenirken, bazı taşlarda ise değişiklik olmadı. Dölek, vatandaşları analiz sonuçlarına kadar sudan içmemeleri yönünde uyardı.
'KAYNAĞIN YANINA UYARICI TABELA ASILMALI'
Dr. İskender Dölek'in aldığı numunelere yapılan analizlerin sonuçlarına ait rapor tamamlandı.
Uluslararası akredite bir laboratuvarda yapılan analizde, suda yoğun miktarda bakteri bulunduğu belirlendi. Suyun içilebilir olmadığına dikkat çeken Dölek, "Sudan numune aldığım zaman analiz sonuçları çıkılmadan 'içilmesin' diye söylemiştim. Bu suyun insan sağlığı için zararlı olabileceğini ifade etmiştik. Sonuçlar da söylediğimizi teyit eder vaziyette. Suda yüzde 300 oranında nitrat olduğu belirlendi. Nitratın kaynağını bilmiyoruz ama gübreden ya da insan atıklarından olabilir. Suda çok yoğun miktarda bakteri var. Kireç oranı da hayli yüksek. Bu su içilebilir bir su değil. Bu tür içeriği bilinmeyen suların analizleri yapılmadan tüketilmemesi insanların sağlıkları için önemlidir. Sağlık müdürlüğü ya da valilik bu suyun tüketilmemesi konusunda uyarı yapmalı. Suyun çıktığı kaynağın yanına uyarıcı tabelalar asılmalı" diye konuştu.

'BU SUYUN ŞİFASINI BULANLAR VAR'
Ancak vatandaşlar sudan içmeye devam ediyor. Gümüşali köyüne Adıyaman'dan böbrek hastası yakınını getiren Ekrem Gürler, "Suyun böbrek taşına iyi geldiğini hepimiz duyuyoruz. Buraya gelip, şifa bulan çok kişi var. Böbrek taşı olanlar genellikle bu suyu içiyor. Su iyi mi kötü mü, bilemiyoruz. Biz şifayı Allah’tan bekliyoruz. Ama vesile olsun diye de bu suyu içiyoruz. Allah şifa versin gelenlere, içenlere. Bu suyun şifasını bulanlar var" dedi.
Gümüşali köyü sakinlerinden Seyithan Arslanşen de "Bu su, şifalı olarak bilinen bir su. Böbrek sancısı çeken bu sudan içiyor. Bazıları suyun iyi geldiğini söylüyor. Uzmanlar suda bakteri olduğunu söylüyor ancak şifa arayanlar hala geliyor" diye konuştu.







Türkçe karakter kullanılmayan ve büyük harflerle yazılmış yorumlar onaylanmamaktadır.